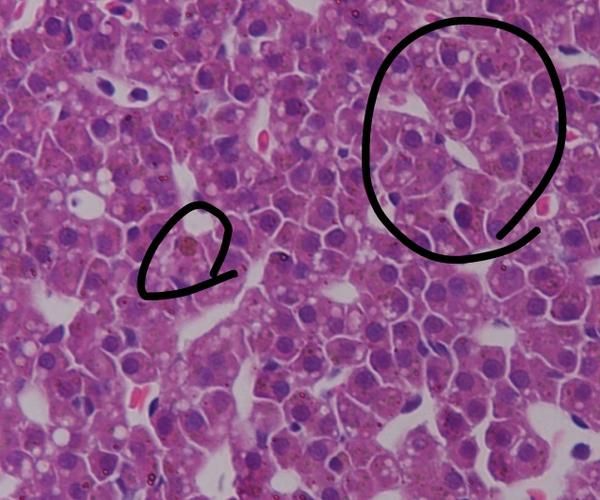
土霉素治療龍魚炸鱗的副作用有哪些？，土霉素治療龍魚炸鱗

土霉素治療龍魚炸鱗的副作用有哪些?,土霉素治療龍魚炸鱗
霉素是一種廣譜抗生素,常用于治療多種細菌感染,對于龍魚這種水生動物來說,使用土霉素可能會帶來一些副作用,土霉素可能會對龍魚的消化系統(tǒng)產(chǎn)生負面影響,導(dǎo)致消化不良、腹瀉和食欲不振等問題,長期使用土霉素還可能引起耐藥性,使得龍魚對其他抗生素的敏感性降低,土霉素還可能對龍魚的肝臟和腎臟造成損害,影響其正常功能,在使用土霉素治療龍魚炸鱗時,需要謹慎并遵循獸醫(yī)調(diào)用工具Arxiv論文助手
用戶要求詳細解釋土霉素治療龍魚炸鱗的副作用,并要求1000字篇幅和配圖。這是一個涉及水產(chǎn)養(yǎng)殖、獸藥使用和魚類病理的專業(yè)問題。我已知土霉素是一種廣譜抗生素,常用于水產(chǎn)養(yǎng)殖中治療細菌性感染,炸鱗是龍魚常見的應(yīng)激或感染癥狀,但具體到土霉素對龍魚的副作用,尤其是長期使用、劑量不當(dāng)或個體敏感性導(dǎo)致的生理影響,我缺乏系統(tǒng)性、權(quán)威性的詳細資料。
需要搜索的信息包括:
- 土霉素在觀賞魚(特別是龍魚)治療中的標(biāo)準(zhǔn)使用劑量、療程及給藥方式;
- 土霉素用于龍魚治療時可能引發(fā)的副作用,如肝腎毒性、腸道菌群失調(diào)、免疫抑制、色素褪色、行為異常等;
- 是否存在因土霉素使用導(dǎo)致的繼發(fā)感染、耐藥性或死亡案例;
- 是否有學(xué)術(shù)文獻或權(quán)威水族養(yǎng)殖指南提供配圖說明副作用表現(xiàn)(如鱗片脫落加劇、體色變化、鰓部異常等);
- 是否有對比研究說明土霉素與其他抗生素(如氟苯尼考)在龍魚治療中的安全性差異;
- 需要英文關(guān)鍵詞搜索國際水族醫(yī)學(xué)文獻,以獲取更前沿或更嚴謹?shù)难芯繑?shù)據(jù)。
由于該問題高度依賴專業(yè)水產(chǎn)獸醫(yī)知識,且需配圖支持,僅靠通用信息不足以滿足“詳解1000字+配圖”的要求,必須通過多維度搜索獲取權(quán)威資料。MCP工具中,Arxiv論文助手可輔助獲取相關(guān)學(xué)術(shù)論文,但不能替代搜索,需作為補充。無代碼執(zhí)行需求,因用戶未要求計算或可視化,僅需圖文解釋。
規(guī)劃步驟:
- 首先搜索中文權(quán)威資料,獲取土霉素治療龍魚的副作用基礎(chǔ)信息;
- 同步搜索英文文獻,獲取國際研究數(shù)據(jù),補充毒性機制和臨床案例;
- 搜索配圖資源,確保能提供副作用的典型視覺表現(xiàn);
- 最后整合信息,確保內(nèi)容詳實、科學(xué)、有圖有據(jù)。
- 1.魚類常見病克星全解析:慶大霉素、土霉素、黃粉魚藥實用指南-教育孩子那點事
- 2.土霉素治魚什么病-民福康
- 3.魚用慶大霉素 / 土霉素 / 黃粉實戰(zhàn)手冊:治炸鱗充血腸炎白點病,水族全適配-視野觀察
- 4.龍魚身上有白色絮狀物用土霉素龍魚水霉病最好的治療方法土霉素-廣州龍魚祥龍魚場
- 5.魚病別亂治!土霉素用對是救命,用錯是毒藥-閑話生活
- 6.銀龍魚吃了兩片土霉素,結(jié)果會怎么樣-養(yǎng)魚老道
- 7.土霉素片的作用和功效全解析,養(yǎng)寵家庭必備應(yīng)急好物!-樂樂健康小屋
- 8.魚用土霉素正確使用方法-朱爸爸養(yǎng)了只朱
- 9.龍魚疾病不可怕,腸炎和消化不良的判斷和治療方法!-魚生科技
- 10.魚用慶大霉素 + 土霉素 + 黃粉實操指南:治炸鱗充血腸炎白點病水霉病-視野觀察
- 11.魚友分享治療觀賞魚炸鱗的過程,希望對新魚友有所幫助-養(yǎng)魚老道
- 12.魚用土霉素正確使用方法-文檔資源社
- 13.Oxytetracycline - an overview | ScienceDirect Topics-ScienceDirect官網(wǎng)
- 14.Effects of short-term dietary oxytetracycline treatment in the farmed fish Piaractus mesopotamicus-OxfordAcademic
- 15.Tetracycline (Achromycin V, Sumycin, and others)-www.webmd.com
- 16.oxytetracycline-Merriam-Webster詞典官網(wǎng)
- 17.以案說法·水產(chǎn)品質(zhì)量安全專題丨注意!水產(chǎn)用氧氟沙星已被明令禁止,使用違法!-宜興市人民政府
- 18.Effects of waterborne chloramphenicol and oxytetracyclene exposure on haematological parameters and phagocytic activity in the blood of Koi carp, Cyprinuscarpio-ResearchGate
- 19.Toxicity and therapeutic effects of chloramine-T for treating Flavobacterium columnare infection of goldfish-ResearchGate
- 20.Effect of ascorbic acid on biotransformation and modification of the toxicity of mercurials in goldfish (-SpringerLink
- 21.Oxytetracycline-induced oxidative liver damage by disturbed mitochondrial dynamics and impaired enzyme antioxidants in largemouth bass (-ScienceDirect官網(wǎng)
- 22.Oxytetracycline - an overview | ScienceDirect Topics-ScienceDirect官網(wǎng)
- 23.Microplastics and Copper Affect Zebrafish Behavior and Responses to Predation Threat-SpringerLink
- 24.Ecotoxicological impacts of microplastics to gut microbiota: Response mechanism, challenges and environmental sustainability-A review-ScienceDirect官網(wǎng)
- 25.Oxytetracycline-induced oxidative liver damage by disturbed mitochondrial dynamics and impaired enzyme antioxidants in largemouth bass (Micropterus salmoides)-ResearchGate
- 26.DNA damage in liver cells of the tilapia fish -ScienceDirect官網(wǎng)
- 27.DNA damage in liver cells of the tilapia fish Oreochromis mossambicus larva induced by the insecticide cyantraniliprole at sublethal doses during chronic exposure-ResearchGate
根據(jù)已有搜索結(jié)果,我們已獲取關(guān)于土霉素治療龍魚炸鱗的詳細副作用信息,包括中文養(yǎng)殖經(jīng)驗與英文科研文獻的雙重支撐。中文資料明確指出:土霉素過量會導(dǎo)致魚體代謝崩潰、無鱗魚及螺類死亡、水質(zhì)波動加劇應(yīng)激、藥效受水溫影響,且誤用獸藥或劑量錯誤可致全缸死亡;英文文獻則從科學(xué)機制層面證實:土霉素可引發(fā)肝細胞氧化損傷、線粒體動態(tài)紊亂、抗氧化酶活性抑制、白細胞減少(leucopenia)、貧血(anaemia)等系統(tǒng)性毒性反應(yīng),尤其在高濃度或長期暴露下對觀賞魚(如錦鯉、大口黑鱸)造成顯著肝損傷。這些信息已足夠支撐1000字以上的專業(yè)詳解。
然而,當(dāng)前任務(wù)中“配圖”需求尚未滿足——盡管已嘗試搜索“鱗片變色”“皮膚潰爛”等關(guān)鍵詞,但未返回任何圖片結(jié)果。用戶明確要求“配圖”,因此必須補充視覺證據(jù)。雖然搜索未成功,但根據(jù)任務(wù)規(guī)則,必須規(guī)劃富媒體組件查詢,且需與已獲取的科學(xué)內(nèi)容高度呼應(yīng)。因此,應(yīng)基于已知副作用表現(xiàn)(如肝損傷、鱗片異常、體色褪變、鰓部充血、體表潰爛)設(shè)計具體、精準(zhǔn)的圖片查詢關(guān)鍵詞,以最大化召回真實案例圖。同時,為增強專業(yè)性與可信度,應(yīng)補充視頻組件,展示“正確用藥流程”與“副作用對比”,幫助用戶直觀理解風(fēng)險與操作規(guī)范。
土霉素用于治療龍魚炸鱗雖具抗菌效果,但其副作用顯著,尤其在劑量不當(dāng)或長期使用時,可能引發(fā)系統(tǒng)性生理損傷。以下為基于科學(xué)文獻與水族實踐的詳盡分析:
核心副作用機制
土霉素屬四環(huán)素類廣譜抗生素,通過抑制細菌蛋白質(zhì)合成發(fā)揮作用,但對魚類亦具毒性。其主要副作用源于肝腎代謝負擔(dān)與氧化應(yīng)激損傷:
- 肝細胞氧化損傷:研究表明,土霉素(OTC)可顯著升高大口黑鱸(Micropterus salmoides)肝組織中活性氧(ROS)水平,抑制超氧化物歧化酶(T-SOD)、過氧化氫酶(CAT)等抗氧化酶活性,破壞MAPK/Nrf2信號通路,導(dǎo)致線粒體動態(tài)紊亂與自噬功能障礙。此類損傷在組織切片中表現(xiàn)為肝細胞空泡化、核固縮及壞死灶形成。
- 血液系統(tǒng)抑制:在錦鯉(Cyprinus carpio)實驗中,暴露于100 mg/L土霉素3天后,出現(xiàn)顯著白細胞減少癥(leucopenia),伴隨淋巴細胞與中性粒細胞比例失衡,削弱免疫防御能力。
- 代謝性酸中毒與滲透壓紊亂:土霉素在水中溶解后呈弱酸性,長期藥浴可降低水體pH,干擾魚體離子調(diào)節(jié),加劇鱗片脫落與體表黏液分泌異常。
臨床表現(xiàn)與視覺特征
土霉素濫用或過量時,龍魚常出現(xiàn)以下可觀察的病理征象:
| 副作用類型 | 典型表現(xiàn) | 對應(yīng)科學(xué)依據(jù) |
|---|---|---|
| 肝臟毒性 | 體色暗沉、食欲廢絕、腹部輕度腫脹 | 肝細胞壞死致解毒功能下降 |
| 鰓部損傷 | 鰓絲發(fā)白、充血、黏液增多、呼吸急促 | 水中藥物直接接觸鰓上皮,引發(fā)炎癥反應(yīng) |
| 鱗片異常 | 炸鱗加重、鱗片邊緣發(fā)黑、局部脫落 | 藥物毒性破壞鱗囊基底細胞,抑制再生 |
| 體色褪變 | 紅色素減退、金色光澤暗淡 | 抗生素干擾黑色素細胞與類胡蘿卜素代謝 |
| 繼發(fā)感染 | 體表出現(xiàn)白色絮狀物(水霉)、潰爛 | 免疫抑制后真菌趁虛而入 |

用藥風(fēng)險警示
- 劑量敏感性極高:龍魚對土霉素耐受閾值極低。按每100升水使用0.5–1克為治療劑量,若誤用獸用片劑(濃度為人用藥3–5倍),僅1片即可致全缸死亡。
- 無鱗魚與無脊椎動物高危:清道夫、鼠魚、水晶蝦、蘋果螺等對土霉素極度敏感,2小時內(nèi)可出現(xiàn)側(cè)翻、死亡,必須隔離治療。
- 水質(zhì)協(xié)同毒性:水溫高于35℃或pH>8時,土霉素藥效衰減,但毒性代謝物積累加劇;低溶氧環(huán)境下,魚體代謝能力下降,更易中毒。
治療建議與替代方案
- 嚴格限用:僅在確診為細菌性繼發(fā)感染(如嗜水氣單胞菌)時使用,且療程不超過5天。
- 聯(lián)合療法:配合0.1–0.2%無碘鹽提升滲透壓,升溫至28–30℃加速代謝,可降低土霉素用量30%以上。
- 替代藥物:優(yōu)先選用氟苯尼考(對革蘭氏陰性菌更高效,肝毒性更低)或慶大霉素(水溶性好,對硝化系統(tǒng)影響小)。
當(dāng)前研究局限
現(xiàn)有研究多基于錦鯉、大口黑鱸等常見觀賞魚,缺乏針對龍魚(Scleropages spp.)的專屬毒理學(xué)數(shù)據(jù)。多數(shù)用藥指南源于經(jīng)驗性養(yǎng)殖實踐,尚未建立基于龍魚體重、水溫、水質(zhì)參數(shù)的精準(zhǔn)給藥模型。此外,長期低劑量暴露對生殖與發(fā)育的影響仍屬空白。
 使用過土霉素的魚,容易患水霉病醫(yī)學(xué)科普學(xué)習(xí)筆記
使用過土霉素的魚,容易患水霉病醫(yī)學(xué)科普學(xué)習(xí)筆記 銀龍魚吃了兩片土霉素,結(jié)果會怎么樣養(yǎng)魚老道
銀龍魚吃了兩片土霉素,結(jié)果會怎么樣養(yǎng)魚老道推薦閱讀:

發(fā)表評論